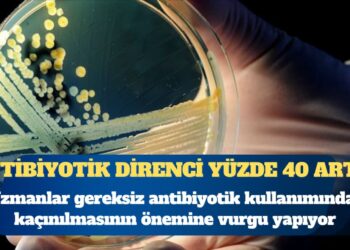

Prof. Dr. Alpay Azap, “Aşılanma ve birkaç ay içinde kullanıma girecek yeni ilaçlar sayesinde covid pandemisinin 6-9 ay içinde endemik yani mevsimsel bir hastalığa dönüşeceğini tahmin ediyoruz” dedi.
Türk Klinik Mikrobiyoloji ve İnfeksiyon Hastalıkları Derneği (KLİMİK) Başkanı Prof. Dr. Alpay Azap, korona virüsü pandemisinin endemik bir hastalığa dönüşeceğini tahmin ettiklerini söyledi ancak aşıdan kaçan yeni bir varyant çıkmasının en az 1 yıl kaybettireceği uyarısında bulundu.
KLİMİK tarafından İstanbul’da düzenlenen ve tüm Türkiye’den enfeksiyon hastalıkları ve klinik mikrobiyoloji uzmanı 400’e yakın hekimin katıldığı “KLİMİK COVID-19 Sempozyumu”nda SARS-COV-2 virüsü son bilimsel gelişmelerle bütün yönleriyle ele alındı.
Düzenlenen basın toplantısına KLİMİK Başkanı Prof. Dr. Alpay Azap, Genel Sekreteri ve Sağlık Bakanlığı Bilim Kurulu Üyesi Prof. Dr. Serap Şimşek Yavuz, Dernek Yönetim Kurulu Üyeleri Prof. Dr. Bülent Ertuğrul, Doç. Dr. Süda Tekin ve Prof. Dr. Neşe Demirtürk ile Doç. Dr. Mehtap Aydın katıldı. Basın toplantısında konuşan Prof. Dr. Alpay Azap, ‘2 yıl öncesine baktığımızda Covid-19’da geldiğimiz noktanın oldukça iyi olduğunu söyledi. Azap, “Oldukça etkili aşılara sahibiz. Elbette hastalığın tüm dünyada kontrol altına alınabilmesi için ülkelerde eşit ve yaygın aşılama son derece önemli. Bu sağlanana kadar da aşıyla birlikte diğer önlemlerin de devam etmesi gerekiyor” dedi.
“MU VARYANTI HENÜZ ‘ENDİŞE VARYANTI’ KATEGORİSİNDE DEĞİL”
SARS-CoV-2’nin beklenenden daha fazla mutasyon geçirmesinin en önemli nedenlerinden birinin, enfeksiyonun kontrolsüz bir şekilde hızla yayılması olduğuna dikkat çeken Prof. Dr. Azap, şu ana kadar 4 adet ‘endişe yaratan varyant’ tanımlanmış olduğunu ancak Mu varyantının henüz bunlardan biri olmadığını söyledi.
Prof. Dr. Azap, “Ancak dikkatle takip edilmesi gereken bir varyant. Delta’nın bulaşma hızı ile kıyaslandığında Mu varyantı yarışı kaybediyor. Delta çok daha bulaşıcı olduğu için Mu varyantının toplumdaki yayılımını baskılıyor. Ama Mu varyantının da (kendi açıcından) şöyle bir avantajı var, ön veriler de bunu söylüyor, Delta’ya nazaran aşılara biraz daha dayanıklı. Aşılanmış veya hastalığı geçirmiş kişilerde, Delta’ya kıyasla daha avantajlı bu bakımdan. Delta gibi birkaç ay içerisinde bütün topluma yayılmıyor henüz. Düşük bir oranda, yüzde 10’un altında seyrediyor görüldüğü ülkelerde. Ama şöyle bir tehdit var, o yüzden çok yakın izliyoruz, insanlarda dolaşmaya devam ettiği için hastalık yaptıkça değişime uğrama riski var. Üzerinde mutasyon biriktirme riski var ve bu kazandığı yeni mutasyonlar onu Delta’dan daha avantajlı hale getirebilir yayılım açısından. Birdenbire nasıl Delta Alfa varyantını süpürdüyse Mu varyantı da Delta’yı süpürebilir ve bu da aşıların etkisini azaltabilir. İşte bizim bütün gayretimiz, bütün dünyanın gayreti, aşıdan kaçan daha bulaşıcı varyantlar çıkmadan önce salgını kontrol altına alabilmek” diye konuştu.
“KÖTÜ AŞI YOK, SADECE UZUN SÜRE KORUMA DOZLARINI HENÜZ BİLMİYORUZ”
Prof. Dr. Alpay Azap, şu an kullanımda olan aşıların hiçbirisi için “kötü aşı” olarak nitelendirilemeyeceğini söyleyerek sözlerini şöyle sürdürdü: “Şu anda acil kullanım onayı almış 12 farklı aşının hepsi, DSÖ’nün istemiş olduğu yüzde 50’den daha fazla korumayı sağlıyor. Ama bütün aşılar için şöyle bir sorun var, henüz bir insanı uzun süreli hastalıktan koruyacak primer doz şeması belli olmadı. Örneğin bu, Hepatit B için 0, 1 ve 6. aylarda yapılan 3 doz aşıdır. Hepatit A için 0 ve 6. aylarda yapılan 2 doz aşıdır. Bizim ülkemizde uygulanan her iki aşı için de bir 3. doz gerekliliği var gibi görünüyor. Ama bu 3. dozun aralığı inaktif virüs aşısında (Sinovac) bağışıklık daha erken azaldığı için 3 ay gibi makul görünürken BioNTech için 8-9 ay olacak gibi görünüyor.”
“SEYAHAT İÇİN 4. DOZ OLMAZ, DÜNYADA BUNUN DÜZELTİLMESİ LAZIM”
Belli risk grubu dışındakiler için BioNTech aşısında iki dozun üzerine 3. dozun henüz gerekli olmadığını da vurgulayan Prof. Dr. Azap, “Çünkü mRNA aşılarında 2 dozun da ağır hastalık ve ölümden korumaya etkisi epeyce uzun devam ediyor. Ama bazı risk gruplarına yapılması faydalı olabilir. Zaten dünyadaki pek çok ülke bunu yapıyor, DSÖ de tam olarak bunu söylüyor. Zira dünya’nın tamamında aşılamayı belli bir orana ulaştıramadan üçüncü dozlara geçseniz bile, aşılanmanın düşük yapıldığı ülkelerde virüs değişime uğrayıp aşıdan kaçabilir hale gelecek. Ondan sonra da siz toplumun yüzde 90’ını 3 doz aşılsanız bile insanlar hasta olacak. Bütün aşılama çöpe gitmiş olacak. Biz KLİMİK Derneği olarak da zaten özellikle Sinovac sonrası 3. Dozunu BioNTech ile olanların 4 dozdan kaçınması gerektiğine dikkat çektik. Maalesef dünya bu konuda çok kötü bir sınav veriyor. Seyahat gerekliliği yüzünden insanlar gerekmediği halde 4. dozlarını olmak zorunda kalıyorlar. DSÖ gibi kurumların bunu düzeltmesi lazım” şeklinde konuştu.
“AŞILANAN İKİ KAT DAHA AZ BULAŞTIRIYOR, SEKEL KALMADAN İYİLEŞİYOR”
Aşı karşıtlarının “Aşılananlar da bulaştırıyor, hastalanıyor, aşı işe yaramıyor” iddialarına da yanıt veren Prof. Dr. Azap, sözlerini şöyle sürdürdü: “Bu çok yanlış. Aşılananlar hastalansa da her zaman aşılanmayanlara göre daha az bulaştırıyor. İngiltere’de çok güzel bir çalışma şunu gösterdi bize, aşılanmış bir birey hastalansa aynı hanede ev halkına hastalığı bulaştırma riski aşısızlara göre yarı yarıya düşük. Yani bir evde 4 kişi yaşıyorsa, aşılanmamış biri hastalığı 2 kişiye bulaştırırken aşılı birey sadece 1 kişiyi enfekte ediyor. ‘Nasıl olsa hastalanacağım’ diye bir şey yok. Hastalanma olasılığınızı da yüzde 60’dan fazla azaltıyor tüm aşılar. Ayrıca hastalansanız dahi kesin olarak hafif geçirmenizi sağlıyor. Hastalığı şiddetli geçirdiğiniz zaman hasar kalma riski çok daha yüksek. Akciğerlerde hasara, felç gibi, kalp krizi gibi durumlara sebep olabiliyor. Dolayısıyla hafif geçirdiğiniz zaman, bunlardan da korunuyorsunuz.”
“YENİ İLAÇLAR DA PANDEMİNİN BİTİŞİNE YARDIM EDECEK”
Dünyada aşılamanın hızlanması, aşılama oranlarının artması ve en önemlisi bu virüsü etkili bir şekilde durdurabilecek ve ağızdan kullanılacak hap şeklindeki kolay uygulanabilecek ilaçların da birkaç ay içerisinde kullanıma girecek olması sayesinde Covid-19 pandemisinin ‘endemiye’ dönüşeceğini düşündüğünü vurgulayan Prof. Dr. Azap, şunları söyleyerek sözlerini noktaladı:
“6-9 ay içerisinde bu hastalığın pandemiden çıkıp endemik bir hastalığa, yani kışın artan, yazın azalan tıpkı grip gibi bir hastalığa dönüşme olasılığı var. Ama bunu belirleyen en kritik faktör, yeni bir varyantın ortaya çıkmaması. Dünya önümüzdeki senenin ortaları veya sonuna doğru atlatmış olabilir pandemiyi. Hatta gelişmiş ülkeler, bizim ülkemiz de dahil, önümüzdeki yılın ortalarından önce atlatabiliriz pandemiyi. Ama aşıdan kaçan bir varyant çıkarsa, bize fazladan en az 1 yıl daha kaybettirir. Bu yeni varyantı engellemenin de tek yolu, insanların hastalanmasını önlemekten geçiyor. Bu da DSÖ pandemi bitti diyene kadar kişisel önlemlere, maske mesafe temizlik, havalandırma önlemlerine dikkat etmek, kalabalıkların bir araya gelmesini engelleyecek toplumsal kısıtlamaların bir süre daha sürdürülmesi ve en önemlisi de yaygın bir şekilde aşılamanın gerçekleştirilmesi ile olabilir.”